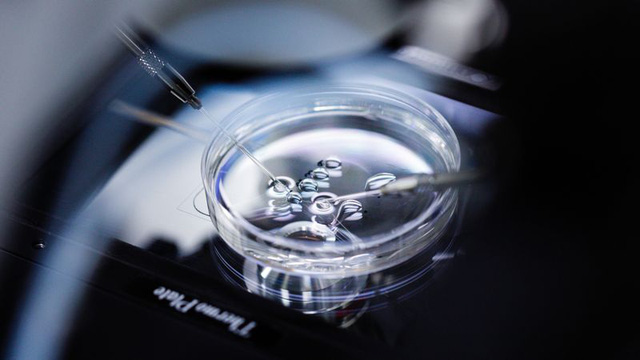

Ngành kinh doanh lạ trị giá 15 tỷ USD khiến hàng loạt DN Mỹ, Úc nhảy vào chia nhau "miếng bánh" béo bở tại Trung Quốc
Sau nhiều năm giới hạn các cặp vợ chồng cho việc chỉ sinh 1 con, Trung Quốc đã nới lỏng lệnh cấm này nhằm đối phó với tình trạng lão hóa dân số cũng như suy giảm nguồn nhân lực giá rẻ từ nông thôn. Tuy nhiên, hàng loạt những nguyên nhân như lượng tinh trùng thấp, sinh đẻ muộn hay các vấn đề sức khỏe khác đã khiến nhiều cặp đôi không thể có con.
Vào một buổi chiều đẹp trời tại bệnh viện Bắc Kinh BPFH, doanh nhân Zhang, 38 tuổi đến từ miền Bắc Trung Quốc ngồi chờ trong hành lang bệnh viện. Vị doanh nhân thành đạt này đã xây dựng được một cơ ngơi đồ sộ với người vợ nhưng lại không thể có con do tinh trùng của ông bị ảnh hưởng từ việc hút thuốc quá nhiều.
Hệ quả là vợ chồng ông Zhang cũng như hàng triệu cặp đôi Trung Quốc khác đã phải tham gia thị trường kinh doanh tinh trùng trị giá 15 tỷ USD.
 |
Việc ngày càng nhiều các cặp đôi Trung Quốc bị vô sinh do vấn đề sức khỏe, ô nhiễm môi trường hay tuổi tác đã khiến rất nhiều doanh nghiệp từ Australia đến Mỹ nhảy vào thị trường này để kiếm lợi nhuận. Với quan niệm truyền thống về nối dõi tông đường hay văn hóa gia đình, những hộ giàu có nhất của quốc gia hơn 1,3 tỷ dân này sẵn sàng chi rất nhiều tiền để có con.
Trong trường hợp của ông Zhang, vị doanh nhân này cho biết mình đã chi 100.000 Nhân dân tệ (14.700 USD) cho mỗi vòng thụ tinh trong ống nghiệm tại bệnh viện.
Trước khi chính quyền Bắc Kinh cho phép các cặp vợ chồng thành thị Trung Quốc có 2 con, chính sách chỉ được có 1 con đã tồn tại nhiều thập niên và chính điều này khiến lực lượng lao động giá rẻ tại đây co lại. Giờ đây, khi điều kiện kinh tế khá hơn, những buổi tiệc tùng liên hoan làm ăn đã khiến nhiều hộ giàu có vô sinh và điều này làm bùng lên ngành kinh doanh thụ tinh nhân tạo.
Số liệu của BIS Research cho thấy ngành thụ tinh nhân tạo tại Trung Quốc năm 2016 có giá trị khoảng 670 triệu USD nhưng được dự đoán sẽ tăng lên 1,5 tỷ USD vào năm 2022.
Trong khi đó, hãng Hua Chuang Securities nhận định nếu khoảng 65% các cặp vô sinh tại Trung Quốc chấp nhận thụ tinh nhân tạo thì với chi phí bình quân 40.000 Nhân dân tệ mỗi vòng, thị trường này có thể có giá trị lên đến 107 tỷ Nhân dân tệ, tương đương 15,76 tỷ USD.
 |
Báo cáo của CFR cho thấy chất lượng tinh trùng của nam giới tại Trung Quốc đã giảm nhanh chóng từ mức 100 triệu con tinh trùng trên mỗi ml vào đầu thập niên 1970 xuống chỉ còn 20 triệu con/ml vào năm 2012.
Nguyên nhân chủ yếu của tình trạng này là do sự căng thẳng trong công việc, tình trạng ô nhiễm môi trường, kết hôn muộn, sử dụng nhiều rượu bia…
Tồi tệ hơn, một nghiên cứu đăng trên tạp chí Fertility & Sterility vào năm 2015 cho thấy chỉ có khoảng 18% số người thử nghiệm tại Trung Quốc là đủ khỏe mạnh để hiến tinh trùng, thấp hơn rất nhiều so với mức 56% khảo sát vào năm 2001. Trong khi đó, nhiều phụ nữ Trung Quốc hiện nay lại có xu hướng đẻ muộn do bận tập trung vào sự nghiệp, qua đó khiến tỷ lệ mang thai ngày càng đi xuống.
Dẫu vậy, nhu cầu có con tại Trung Quốc là rất cao và chính điều này đã thúc đẩy các tập đoàn quốc tế muốn thâm nhập thị trường này.
Hãng Virtus Health của Australia là một công ty chuyên kinh doanh trong mảng chữa trị vô sinh. Tuy nhiên họ khó lấy được giấy phép kinh doanh tại Trung Quốc do các rào cản về luật pháp và bảo hộ. Bởi vậy, tập đoàn này đã hợp tác với các hãng môi giới du lịch để đưa khách hàng đến những phòng khám của hãng tại Australia và Singapore để thực hiện.
Trong khi đó, trung tâm Southern California Reproductive Center tại Mỹ cũng cho biết khoảng 20% khách hàng của họ trong năm qua là người Trung Quốc.
|
Tại thị trường nội địa, ngành kinh doanh thụ tinh nhân tạo cũng phát triển nhưng còn gặp nhiều hạn chế do quy định của pháp luật. Hãng United Family Healthcare thuộc tập đoàn Shanghai Fosun cho biết các cơ sở thụ tinh nhân tạo công tại Trung Quốc đang bị quá tải và chúng khiến bệnh nhân cảm thấy tiêu cực khi phải chờ đợi cũng như phiền phức trong khâu làm thủ tục.
Thêm vào đó, quy định của Trung Quốc không cho phép các phụ nữ trẻ hiến trứng hoặc làm đông trứng của mình để có thể thụ tinh nhân tạo trong tương lai. Những quy định kiểu này khiến rất nhiều người quyết định ra nước ngoài sử dụng dịch vụ hơn là làm trong nước.
Ủy ban Y tế và Kế hoạch hóa Gia đình Trung Quốc (NHFPC) cho biết tính đến năm 2016, toàn quốc đã có 451 ngân hàng tinh trùng cũng như cơ sở y tế được cấp phép chăm sóc sinh sản, nhưng con số này chưa thấm gì so với nhu cầu tại quốc gia hơn 1,3 tỷ người này.
“Dịch vụ sinh sản nhân tạo là một trong những ngành có tiềm năng tăng trưởng nhanh nhất trong mảng y tế”, báo cáo tháng 1/2017 của Haitong Securities cho biết.
Trung Quốc thiếu, Đan Mạch thừa
Nghiên cứu năm 2015 cho thấy chưa đến 1/5 số nam giới tại tỉnh Hồ Nam-Trung Quốc là đủ tiêu chuẩn để hiến tinh trùng, thấp hơn rất nhiều so với mức hơn 50% vào năm 2001.
Trong khi đó, giới truyền thông tại tỉnh Hà Nam cho biết lượng tinh trùng dự trữ lại đây đã xuống mức thấp kỷ lục và thậm chí ngân hàng tinh trùng đã phải đưa ra chương trình bảo lưu miễn phí trong 30 năm nhằm kích thích những người đi hiến.
Khảo sát năm 2014 của Ngân hàng thế giới (World Bank) cho thấy tỷ lệ sinh (số trẻ em bình quân mỗi người phụ nữ sinh ra trong thời kỳ sinh đẻ) tại các khu vực như Hong Kong, Ma Cao là 1,2 trẻ/phụ nữ và của toàn Trung Quốc là 1,6 trẻ/phụ nữ. Con số này thấp hơn rất nhiều so với tỷ lệ bình quân toàn cầu là 2,5 trẻ/phụ nữ cũng như thấp hơn mức 2,1 trẻ/phụ nữ cần thiết để duy trì mức tăng trưởng dân số tại Trung Quốc.
 |
Năm 2015, tỷ lệ sinh sản của Trung Quốc giảm xuống mức thấp kỷ lục 1,05 trẻ/phụ nữ.
Dân số Trung Quốc đang già đi nhanh chóng trong khi tỷ lệ sinh lại đi xuống, từ mức đỉnh 6,4 trẻ/phụ nữ vào năm 1965 xuống 2,8 trẻ/phụ nữ vào năm 1979 khi chính sách 1 con được ban hành trước nỗi lo quá tải dân số.
Theo CFR, tình hình sinh sản của Trung Quốc có vẻ đang khá nghiêm trọng khi tỷ lệ vô sinh chính thức đã bị chính phủ ngừng công bố từ cuối năm 2011, qua đó khiến nhiều chuyên gia nghi ngờ về tình hình dân số của nước này.
Trong khi đó, nghiên cứu độc lập của Human Sperm Quality Research cho thấy Trung Quốc có gần 40 triệu người đang bị vô sinh và dự đoán nhu cầu trong ngành thụ tinh nhân tạo sẽ còn tăng mạnh thời gian tới.
Trái ngược lại, khi Trung Quốc đang đau đầu vì thiếu tinh trùng cùng trứng thì những quốc gia như Đan Mạch lại đang bùng nổ trên thị trường này. Theo tờ Financial Times, bình quân mỗi 0,5 ml tinh trùng tùy chất lượng tại Đan Mạch có giá dao động 40-1.000 Euro.
Sự bùng nổ trong ngành đã biến những công ty kinh doanh tinh trùng như Cryos thành doanh nghiệp lớn có giá trị 1 tỷ DKr (152 triệu USD) vào năm 2012 với doanh số xuất khẩu 700 triệu DKr vào cùng năm.
Báo cáo của European Sperm Bank vào năm 2015 cho thấy Đan Mạch là thị trường đứng đầu thế giới trong ngành tinh trùng. Dù tổng sản lượng xuất khẩu tinh trùng không bằng một số quốc gia nhưng với dân số chỉ 5,5 triệu người, tỷ lệ hiến tinh trùng tại đây lại thuộc hàng top thế giới.
 |
Số liệu của HFEA cho thấy 70% số tinh trùng nhập khẩu của Anh là từ Mỹ nhưng Đan Mạch cũng chiếm gần 1/5 trong số đó và giữ vị trí thứ 2.
Thậm chí, số lượng mua bán tinh trùng tại các nước Phương Tây còn cao hơn nữa khi Cryos cho biết họ thường chuyển thẳng sản phẩm đến cho các khách hàng nữ và họ tự thụ tinh tự nhiên mà không thông qua các cơ sở y tế. Bởi vậy số lượng giao dịch ngầm có thể lớn hơn rất nhiều so với các báo cáo.
Mặc dù nhiều quốc gia đã hạn chế số lượng gia đình mà mỗi chủ thể hiến tinh trùng có thể bán, ví dụ như ở Anh là 10 hộ, nhằm tránh tình trạng thông hôn cùng huyết thống. Dẫu vậy, tình trạng mua bán tinh trùng bừa bãi vẫn diễn ra, một cảnh tượng hoàn toàn trái ngược so với thị trường tiềm năng còn trầm lắng tại Trung Quốc.
BT
Tin bài liên quan
Các tin bài khác

Thời tiết hôm nay (8/4): Nắng nóng gay gắt bao trùm nhiều khu vực

Thời tiết hôm nay (02/4): Bắc Bộ có mưa, Nam Bộ nắng nóng

Thời tiết hôm nay (25/3): Tây Bắc Bộ nắng nóng, Hà Nội mưa rải rác

Thời tiết hôm nay (23/3): Bắc Bộ mưa vài nơi, trưa chiều trời nắng
Đọc nhiều

Duy trì mạch kết nối nhân dân Việt Nam – Slovakia

Tin quốc tế ngày 14/4: Nhiều nước lớn phản hồi lệnh phong tỏa eo biển Hormuz của Mỹ, Tổng thống Philippines bật nhảy, chạy bộ trước truyền thông

Sôi động giải bóng đá người Việt tại Nhật hướng về Trường Sa

Mạng lưới Tài năng Việt – Úc (AVTN) chính thức ra mắt tại Tây Úc
Bờ cõi biển đảo
Miền đất - Con người Cuộc sống vùng biên Nhịp sống biển đảo Lịch sử chủ quyền Giao lưu hữu nghị

Đắk Lắk: Ngư dân ký cam kết chống khai thác IUU

Thực hiện khuyến nghị của EC, nhiều địa phương tăng tốc gỡ "thẻ vàng" IUU

Điện Biên phát động trồng mới cây cà phê, mắc ca tại 42 xã, phường
![[Video] Cử tri cả nước nô nức đi bầu cử đại biểu Quốc hội khóa XVI và HĐND các cấp](https://www.thoidai.com.vn/stores/news_dataimages/2026/032026/15/15/croped/nga-y-ba-u-cu-cover20260315150902.jpg?260316093218)
[Video] Cử tri cả nước nô nức đi bầu cử đại biểu Quốc hội khóa XVI và HĐND các cấp
![[VIDEO] Tinh thần dân chủ của nhân dân Việt Nam trong bầu cử](https://www.thoidai.com.vn/stores/news_dataimages/2026/032026/13/15/croped/pv-da-i-su-la-o-cover20260313153333.jpg?260316091846)
[VIDEO] Tinh thần dân chủ của nhân dân Việt Nam trong bầu cử

Tổ chức Giao lưu Quốc tế Việt Nam Nhật Bản (FAVIJA): thúc đẩy hữu nghị, hợp tác đa phương
![[Video] Vũ điệu chúc xuân sôi động của Đại sứ Hà Lan tại Việt Nam](https://www.thoidai.com.vn/stores/news_dataimages/2026/022026/13/06/croped/video-dai-su-ha-lan-tai-viet-nam-gui-loi-chuc-tet-bang-vu-dieu-soi-dong-20260213062706.jpg?260213053058)
[Video] Vũ điệu chúc xuân sôi động của Đại sứ Hà Lan tại Việt Nam
![[Video] Đại sứ Lào tại Việt Nam tin tưởng Đại hội XIV sẽ tạo động lực mạnh mẽ cho Việt Nam phát triển toàn diện](https://www.thoidai.com.vn/stores/news_dataimages/2026/012026/19/10/video-dai-su-lao-tai-viet-nam-tin-tuong-dai-hoi-xiv-se-tao-dong-luc-manh-me-cho-viet-nam-phat-trien-toan-dien-20260119100621.jpg?rt=20260119100624?260119015548)
[Video] Đại sứ Lào tại Việt Nam tin tưởng Đại hội XIV sẽ tạo động lực mạnh mẽ cho Việt Nam phát triển toàn diện
![[Video] WVIV thúc đẩy nông nghiệp tái sinh, nâng cao sinh kế cộng đồng tại Thanh Hóa](https://www.thoidai.com.vn/stores/news_dataimages/2026/012026/25/12/video-wviv-thuc-day-nong-nghiep-tai-sinh-nang-cao-sinh-ke-cong-dong-tai-thanh-hoa-20260125121019.jpg?rt=20260125121023?260126090118)
[Video] WVIV thúc đẩy nông nghiệp tái sinh, nâng cao sinh kế cộng đồng tại Thanh Hóa
![[Video] Plan International và Tỉnh Đoàn Quảng Trị xây dựng lực lượng thanh niên hành động vì khí hậu](https://www.thoidai.com.vn/stores/news_dataimages/2026/012026/25/12/plan-international-va-tinh-doan-quang-tri-xay-dung-luc-luong-thanh-nien-hanh-dong-vi-khi-hau-20260125120627.jpg?rt=20260125120631?260126090029)
[Video] Plan International và Tỉnh Đoàn Quảng Trị xây dựng lực lượng thanh niên hành động vì khí hậu
![[Video] 10 sự kiện văn hóa, thể thao và du lịch tiêu biểu năm 2025](https://www.thoidai.com.vn/stores/news_dataimages/anhvm/012026/06/17/10_SUYY_KIEYYN_VAYN_HOAY_THEYY_THAO_VAY_DU_LIYCH_TIEYU_BIEYYU_NAYM_2025_mp4_29_12_-_YouTube_11.jpg?260106064252)
[Video] 10 sự kiện văn hóa, thể thao và du lịch tiêu biểu năm 2025

Plan International Việt Nam hỗ trợ khẩn cấp hơn 1,8 tỷ đồng cho người dân Đà Nẵng sau bão

Vietnam Happy Fest 2025: Lan tỏa những giá trị hạnh phúc giữa lòng Hà Nội
![[VIDEO] Tổ chức Cứu trợ Trẻ em tiếp sức trẻ em Bắc Ninh sớm quay về nhịp sống sau thiên tai](https://www.thoidai.com.vn/stores/news_dataimages/2025/122025/06/13/croped/cu-u-tro-bn-2-cover20251206131142.jpg?251206015430)
[VIDEO] Tổ chức Cứu trợ Trẻ em tiếp sức trẻ em Bắc Ninh sớm quay về nhịp sống sau thiên tai
![[Video] World Vision hỗ trợ hơn 1.100 người dân Quảng Ngãi tiếp cận nước sạch bền vững](https://www.thoidai.com.vn/stores/news_dataimages/2025/112025/25/09/dong-tam-doc-suc-cuu-tro-dong-bao-vung-lu-20251125093203.jpg?rt=20251125093457?251125104340)
[Video] World Vision hỗ trợ hơn 1.100 người dân Quảng Ngãi tiếp cận nước sạch bền vững
![[Video] Đồng tâm, dốc sức cứu trợ đồng bào vùng lũ](https://www.thoidai.com.vn/stores/news_dataimages/2025/112025/25/09/dong-tam-doc-suc-cuu-tro-dong-bao-vung-lu-20251125093208.jpg?rt=20251125093211?251125103933)
[Video] Đồng tâm, dốc sức cứu trợ đồng bào vùng lũ
![[Video] Ấn Độ tặng Giải thưởng Hòa bình Romesh Chandra cho bà Nguyễn Thị Bình](https://www.thoidai.com.vn/stores/news_dataimages/2025/112025/18/18/croped/ba-bi-nh-cover20251118184907.jpg?251119023755)
[Video] Ấn Độ tặng Giải thưởng Hòa bình Romesh Chandra cho bà Nguyễn Thị Bình
![[Video] Lễ dâng y Kathina tại Đà Nẵng: Sợi dây gắn kết Phật giáo các nước châu Á](https://www.thoidai.com.vn/stores/news_dataimages/anhvm/102025/15/11/Kathina__1.jpg?251015023951)









